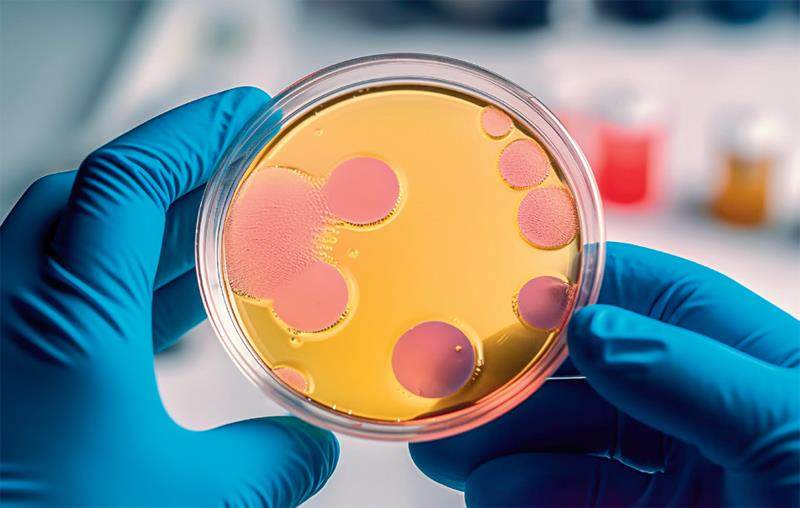

近期,媒体报道一种由“食人菌”引起的严重疾病正在日本蔓延。根据日本国立感染症研究所公布的数据,截至2024年6月23日,日本的“食人菌”感染症病例已达1101例,超过了2023年的941人。有报道称,这种“食人菌”导致的疾病病死率高达30%以上。
我国与日本是邻国,日本也是很多人暑期旅行的目的地。因此,有人担心“食人菌”会威胁我们的健康。下面,我们就来详细了解一下“食人菌”的来历和可能带来的健康风险。
“食人菌”的病原体是A 组β 型溶血性链球菌(GAS),又叫化脓性链球菌。这种细菌并不罕见,也不是新出现的病原体类型。化脓性链球菌通常感染上呼吸道和皮肤软组织,在少数情况下会引发严重的败血症,甚至是更致命的疾病。其中,最严重的就是链球菌中毒休克综合征(STSS),也就是最近引发大家关注的所谓“食人菌”感染症。
链球菌中毒性休克综合征一旦发生, 往往进展迅速, 可在1~2天内导致患者休克和多器官衰竭,30%~60%的患者可能会因抢救无效而死亡。
实际上,化脓性链球菌可能存在于很多健康人的咽喉和皮肤上。这些人身上虽然有化脓性链球菌,但并没有表现出症状,细菌和人体处于和平共存的状态。
咽峡炎 化脓性链球菌可以通过呼吸道进行传播,一些人因此出现急性咽峡炎的症状,比如发热、咽痛、声音嘶哑等。患者很可能出现扁桃体红肿的症状,甚至扁桃体上还有黄白色的脓苔。各年龄段人群都可能染病。
猩红热 化脓性链球菌也是引起猩红热的病原体。猩红热是一种急性呼吸道传染病,一年四季均可发生。在我国,猩红热在5~6月和11~12月多见,发病者以2~15岁的儿童青少年为主,5~9岁儿童更为多见。猩红热主要表现为发热、咽痛和全身红色皮疹,患者也可能出现扁桃体红肿化脓、草莓舌等症状。皮肤上出现猩红色皮疹是此病的主要表现,用手指按压会褪色,皮疹隆起如“鸡皮疙瘩”。猩红热是我国法定传染病中的乙类传染病。一旦发现猩红热病例,就需要按照相关制度进行上报和管理。
皮肤病 很多人的皮肤上有化脓性链球菌,但绝大部分人处于无症状携带状态。一旦皮肤破损,化脓性链球菌就可能从伤口进入人体内,导致皮肤软组织感染,表现为丹毒、蜂窝织炎等疾病,患者通常会有皮肤局部红肿、疼痛的症lLrrm0KhuH0bz6LMN4MQLA==状。
侵袭性感染导致的疾病 通过呼吸道或者皮肤感染化脓性链球菌的人,多数只有局部症状,如果及时给予抗生素治疗,就能顺利康复。但是,少数人会因为细菌进入血液导致败血症、感染性休克等严重的问题。医学上把波及全身的化脓性链球菌感染称为侵袭性感染。侵袭性感染会导致化脓性关节炎、骨髓炎、腹膜炎和脑膜炎。
链球菌中毒休克综合征 链球菌中毒休克综合征以发展迅速、救治难度大、病死率高而引人关注。这种疾病虽然会夺人性命,但它不完全是细菌对人体的破坏,而是细菌激活了人体过度的免疫反应,使人体免疫系统释放了过度的细胞因子,最终导致休克和多器官功能衰竭,其本质是感染诱发的过度炎症反应。
变态反应疾病 化脓性链球菌感染还会诱发一些变态反应相关疾病,如风湿热、肾小球肾炎等。风湿热通常发生在感染化脓性链球菌后3周左右,肾小球肾炎多发生在感染后2~3周,而反应性关节炎常常发生在感染后10天内。
在抗生素被发现以前,化脓性链球菌感染是个严重的问题。不管是儿童的猩红热、成年人的咽峡炎,还是产妇的产褥热,都可能危及患者生命。但有了抗生素之后,化脓性链球菌感染就很少出现危及生命的情况了。截至目前,青霉素、阿莫西林、头孢类抗生素治疗化脓性链球菌感染仍然非常有效。
需要强调的是,患者确诊后,使用抗生素应足量、全程,按照医生的嘱咐完成全疗程。很多患者在接受抗生素治疗2~3天后,症状就会明显好转。提醒大家不要过早停药,这样会有病情复发的风险,还会增加细菌耐药的风险。
化脓性链球菌感染导致呼吸道或者皮肤软组织感染的患者,只要做到早发现、早诊断、早治疗,大部分都能顺利康复。而防治链球菌中毒休克综合征,需要我们对高风险人群进行宣传教育,力争早识别、早治疗。
根据现有的资料,我们发现,有以下危险因素的人群可能是链球菌中毒休克综合征的高风险人群:年龄大于50岁,有糖尿病且血糖控制欠佳,近期有手术史,有皮肤伤口或者皮肤疾病(水痘、带状疱疹、皮肤癣、外伤都可能增加感染的风险),静脉吸毒,恶性肿瘤,肥胖,有外周血管疾病等。
值得注意的是,今年日本报道的链球菌中毒休克综合征患者中,也有部分30~50岁的人,目前尚不清楚这些人发病的风险因素。
由于化脓性链球菌在世界各地都很常见,所以目前并不存在感染范围继续扩大的问题。而链球菌中毒休克综合征的病例大部分是散发的,多通过皮肤伤口感染,并非通过呼吸道感染或者接触感染,所以大家不必过度担忧。赴日旅游只要做好卫生防护,也不需要特别担心。
在此提示大家,今年,我国猩红热病例有所增加,大家应积极预防呼吸道感染,同时加强对学龄儿童的健康监测和科普宣传。儿童如果出现发热、咽痛等不适症状,应及时关注。
如果皮肤上有伤口,就要及时冲洗干净和消毒,用无菌纱布或者创可贴覆盖伤口,减少感染的风险。如果伤口出现红肿、化脓、疼痛等感染现象,就要及时就医。
